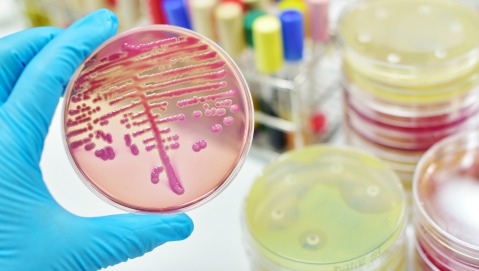

Ancora un caso di meningite, ancora un decesso di una giovane ragazza. La scorsa settimana a Milano a farne le spese è stata una 24enne, originaria di Ferrara, venuta a mancare a causa di un infezione da meningococco C.
Nelle ultime ore è toccato a Susanna, 18 anni, di ritorno dalla Giornata Mondiale della Gioventù svoltasi a Cracovia. Una malattia, la meningite, contro cui la medicina può fare ancora poco. «Anche quando la diagnosi viene fatta tempestivamente, e la terapia antibiotica praticata subito e in maniera adeguata, la possibilità di guarire completamente è inferiore al 50%, spiega Alberto Villani, responsabile di Pediatria Generale e Malattie Infettive dell’Ospedale Pediatrico Bambino Gesù. Per fortuna però da tempo sono disponibili alcuni vaccini in grado di arginare la diffusione della patologia. Una vera e propria arma capace di cambiare la storia della malattia.

MENINGITE IN BREVE
La meningite è una infiammazione del rivestimento del sistema nervoso centrale (cervello e midollo) detto meninge. Le categorie più a rischio sono i bambini nella primissima infanzia e i giovani dai 15-18 anni ai 24-25 anni. Esistono forme batteriche e virali, entrambe possono essere mortali. Il contagio avviene per via aerea, ma occorre un contatto molto ravvicinato. Nella prima fase della malattia, ovvero nelle prime 7-10 ore, i sintomi sono quelli di una normale influenza. Dopo 10 ore le manifestazioni cominciano a caratterizzarsi: mal di testa molto intenso, rigidità del collo e febbre elevata. Nell’ultima fase, tra le 20 e le 36 ore, si presentano i sintomi gravi e tipici della meningite: perdita di conoscenza, convulsioni, macchie sul corpo. «La meningite è una malattia difficile da riconoscere nelle fasi iniziali. La diagnosi viene fatta in genere quando si manifestano i sintomi più tipici e spesso, purtroppo, è già troppo tardi» spiega Villani.
CURA DIFFICILE
In Italia si registrano circa mille nuovi casi ogni anno e 1 persona su 10, tra chi si ammala, muore. 3 su 10 riportano esiti gravi e permanenti. Malgrado i progressi della medicina nella rianimazione e nell'assistenza al paziente, la mortalità non è diminuita e circa il 10% delle persone ammalate perde la vita. Il 50-60% guarisce completamente, mentre il 30% sopravvive riportando conseguenze anche molto gravi (15 bambini su 100 hanno complicanze così gravi da richiedere protesi acustiche o degli arti, cicatrici invalidanti, seri problemi alla vista, deficit neuro-motori) con un costo umano, sociale e sanitario altissimo. La maggior parte dei decessi porta la firma del meningococco C, patogeno di origine batterica (Neisseria meningitidis).
PREVENIRE CON I VACCINI
La prevenzione rimane l’arma principale. Oggi sono disponibili vaccini specifici per la meningite da Haemophilus influenzae di tipo B e per le forme - le più frequenti - causate dallo pneumococco e dai ceppi principali (A, B, C, Y, W 135) del meningococco. Sebbene sia importante seguire l’apposito calendario è possibile vaccinarsi contro la meningite a qualsiasi età. «Vaccinarsi è fondamentale. In mancanza di vaccinazione, infatti, il batterio responsabile della malattia circola di più e, conseguentemente, colpisce in misura maggiore. Chi non si vaccina non danneggia solo se stesso, ma mette a repentaglio anche gli altri. Attualmente accade anche che siano giovani adulti che non hanno effettuato i richiami vaccinali, o anziani non vaccinati, a contagiare bambini e neonati» continua Villani.
COSA FARE SE VENUTI IN CONTATTO?
Attenzione però a non confondere vaccino con profilassi. «In caso di stretto contatto con un soggetto affetto da meningite è possibile proteggersi con una profilassi d’emergenza, ovvero con una terapia antibiotica specifica per il tipo di germe responsabile, su prescrizione dell’autorità sanitaria. La procedura avviata entro le 48 ore dal contatto è efficace e sicura, tuttavia quanto più è precoce è il trattamento, tanto maggiori sono le probabilità che abbia successo e che la malattia guarisca senza esiti», conclude Villani.